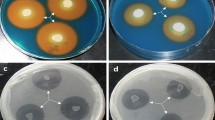

Abstract
The effect of plant growth-promoting bacteria inoculation on Helianthus annuus growth and copper (Cu) uptake was investigated. For this, the strains CC22, CC24, CC30, and CC33 previously isolated from heavy metal- and hydrocarbon-polluted soil were selected for study. These strains were characterized on the basis of their 16S rDNA sequences and identified as Pseudomonas putida CC22, Enterobacter sakazakii CC24, Acinetobacter sp. CC30, and Acinetobacter sp. CC33. Strains were able to synthesize indole, solubilize phosphorus, and produce siderophores in vitro, which are proper characteristics of plant growth-promoting (PGP) bacteria. Bacteria were also able to bioaccumulate Cu(II), and most of them could use aromatic hydrocarbons as a sole carbon source. Furthermore, Acinetobacter sp. CC33 exhibited the greatest extent of Cu(II) accumulation, and CC30 the widest range for degrading hydrocarbons. Acinetobacter sp. CC30 was selected for pot experiments on the basis of its plant growth-promoting properties. Inoculation with CC30 significantly increased the plant biomass (dry weight and length of root and shoot) and improved the photosynthetic pigment content in non- and Cu-contaminated soil (p < 0.05). Additionally, plant Cu uptake was improved by CC30 inoculation showing a significantly enhanced root Cu content (p < 0.05). Our findings evidenced that the strain CC30 protected the plant against the deleterious effect of Cu contamination and improved the Cu extraction by plant, hence concluding that its inoculation represents an alternative to improve phytoremediation process of heavy metals, particularly Cu, in contaminated environments.
Similar content being viewed by others
Explore related subjects
Discover the latest articles, news and stories from top researchers in related subjects.Avoid common mistakes on your manuscript.
1 Introduction
Copper (Cu) is an essential micronutrient for plants (Sommer 1931; Arnon and Stout 1939). However, when it is at high concentrations, it becomes toxic (Ouzounidou 1995). Cu contamination is usually generated by human activities such as smelting, mining, plating, steelworks, refineries, domestic emission, application of fertilizers and fungicides, sewage sludge, etc. (Flemming and Trevors 1989). Excess Cu induces a wide range of biochemical effects and metabolic alterations in plants that are responsible for a strong inhibition of growth, sometimes accompanied by anomalous development (Fernandes and Henriques 1991). Mechanisms through which Cu(II) causes toxicity are related with interactions with biomolecules. Since Cu is a redox-active transition metal, its metabolism might result in the generation of reactive oxygen species. These may lead to unspecific oxidation of proteins and membrane lipids, resulting in an increased concentration of thiobarbituric acid-reacting substances, which are products of lipid peroxidation, thus altering the biological activity of enzymes, modulating intracellular signaling, and exerting damaging effects on biological macromolecules, including DNA (Abdelly et al. 2008). Similarly, Cu can interfere with the structure and activity of certain proteins, likely altering the protein function by binding of the metals to sulfhydryl groups, leading to the inhibition of activity or disruption of the structure (Tanyolac et al. 2007).
Several strategies have been addressed in order to solve this environmental problem (Vandegrift et al. 1992). Nevertheless, those are usually expensive and are sometimes contaminants (Glick 2010). Phytoremediation represents a low-cost and efficient technology to remove heavy metal contamination from highly polluted soils. However, efficiency of a phytoremediation process may be limited by availability of metals in soil, the plant growth, and the plant tolerance to the heavy metal (Cataldo and Wildung 1978). In order to increase the removal of heavy metals from soil, some alternatives have been developed. The most common imply the use of chelator agents such as EDTA, which can enhance metal availability (Turgut et al. 2004, 2005; Evangelou et al. 2007). However, these may become persistent in the environment, leading to contamination of groundwater (Tandy et al. 2006). Some soil microorganisms possess mechanisms that can increase metal availability in soil for plant uptake (Lasat 2002) and may facilitate plant growth either directly or indirectly. Direct mechanisms of plant growth promotion are associated to increasing nutrient availability or regulation mediated by bacterial synthesis of like-phytohormone compounds (Glick 2010). For instance, nitrogen fixation increases the availability of nitrogen in soil, phosphate solubilization enhances phosphorus availability through solubilization of phosphorus insoluble salts or mineralization of organic phosphoric compounds (RodrÌguez and Fraga 1999), and siderophores synthesis that can sequester iron from the soil and provide it to plant cells which can take up the bacterial siderophores–iron complex for its nutrition (Glick 2010). Moreover, microbial synthesis of phytohormones such as auxins, cytokinins, and gibberellins can enhance plant growth by regulating several plant physiological processes (Costacurta and Vanderleyden 1995). Sheng and Xia (2006) exhibited an increase in growth of both root and shoot and cadmium (Cd) accumulation in canola by inoculation with a cadmium-resistant PGPB. In the same way, Ma et al. (2009) showed that inoculation with PGPB Achromobacter xylosoxidans AX10 increased plant growth and copper uptake, likely through indole synthesis, siderophores, and phosphate solubilization. With regard to indirect mechanisms, these are associated to protect plants against phytopathogenic attacks (Glick 2010).
Several reports have elucidated the role of sunflower to remediate heavy metals (Mani et al. 2007; Nehnevajova et al. 2005; Turgut et al. 2004, 2005; Lesage et al. 2005). However, to our knowledge, few attempts have been carried out with the purpose of evaluating the PGPB role on sunflower phytoextraction process. Thus, the purposes of this work were to characterize the plant growth-promoting capabilities of bacteria previously isolated from heavy metal- and hydrocarbon-contaminated soil and to select one to investigate its role on copper phytoextraction process.
2 Materials and Methods
2.1 Strains and Culture Media
The Centro de Investigaciones Microbiológicas at the Universidad de los Andes, Colombia, provided the strains CC22, CC24, CC30, and CC33. These were isolated from a hydrocarbon- and heavy metal-contaminated soil subjected to landfarming process in Trinidad, Casanare, Colombia (5°24′38.42″ N, 71°39′40.34″ W) (Dussán J., unpublished data). We selected them by their intrinsic capacity to synthesize auxins and by their tolerance of more than 2.0 mM Cu(II) on LBM media (composition: tryptone 5.0, yeast extract 5.0, and NaCl 5.0 g/L). Strains were grown on LBM culture media, at 28°C at 150 rpm (standard conditions) and maintained on LBM solid medium at 4°C for routine work.
2.2 Genetic Characterization of the PGPB
CC22, CC24, CC30, and CC33 were grown for 16 h in LB broth at 28°C. From each culture was taken 25.0 μL and transferred to 1.5-mL microtubes. These were submerged in boiling water for 15 min. After, they were centrifuged at 13,000 rpm for 1 min, and 0.9-μL supernatants were used as DNA templates. The 25.0-μL volume reactions of PCR amplifications were performed using an iCycler thermo cycler (Bio-Rad, USA). Negative controls were done using ultra-pure water instead of DNA. PCR assays for primer sets targeting the 16S rDNA region included 0.9-μL template DNA, 2 U of TucanTaq Polymerase (CorpoGen, Colombia), 1× PCR buffer, 2.5 mM MgCl2, 0.2 mM dNTPs, and 0.3 μM of each primer. PCR protocols for 16S rDNA sequence (35-cycle) were performed as previously reported (Fierer and Jackson 2006). A 622-bp fragment was expected and confirmed by taking 5.0-μL aliquots of PCR product and loading them to 1% agarose gels. The primers employed were: 352f (5′ GGT TAC CTT GTT ACG ACT T 3′) and 975r (5′ AGA GTT TGA TCC TGG CTC AG 3′). PCR products were purified using Wizard® SV Gel and PCR Clean-Up System kit (Promega, USA). Purified products were sequenced using the BigDye® Terminator v 3.1 Cycle Sequencing Kit using 325f and 975r primer. The sequence data were then compared to similar sequences in the database using BLAST analysis at NCBI. The 16S rDNA sequences were deposited in the EMBL/GenBank database. These sequences were compared with previously published 16S rDNA sequences from related species. The multiple alignments of sequences were performed with ClustalW software.
2.3 Minimal Inhibitory Concentration to Copper
Minimal inhibitory concentration (MIC) to Cu(II) was tested at 28°C for 120 h on 1× LBM, 0.66× LBM, 0.33× LBM, and MM9 media (Maniatis et al. 1982), in order to evaluate the effect of culture media on the MIC of bacteria to Cu(II). Stock solution was employed at 80 mM for Cu in the form of CuSO4·5H2O (249.68 g mol−1) and sterilized by filtration. For inoculation, strains were grown on LBM for 120 h, washed twice in 0.85% NaCl, and adjusted to OD600 = 0.500, and 30 μL of suspension was employed to inoculate the treatments. The growth was verified spectrophotometrically (Genezy UV 10, Thermo Corporation, USA) at 600 nm (Ma et al. 2009), after 120 h at standard condition.
2.4 Phosphate Solubilization, Indolic Compound Production, and Siderophores Synthesis
2.4.1 Phosphate Solubilization
The bacterial cultures were grown in Pikovskaya medium with tricalcium phosphate at standard conditions for 120 h (Pikovskaya 1948). The supernatants from culture were centrifuged at 10,000 rpm for 10 min. Soluble phosphate in the supernatant was estimated by the phosphomolybdate blue method (Fiske and Subbarow 1925).
2.4.2 Indole Quantification
Indolic compounds were estimated using the colorimetric assay based on the Salkowsky reagent (Glickmann and Dessaux 1995) employing the PC reagent (12 g/L FeCl3 in 7.9 H2SO4). The culture medium employed was K-lactate (Carreno-Lopez et al. 2000); the incubation was carried out for 72 h at 150 rpm in the dark. The reaction between PC reagent and culture supernatant was in relation 1:1 and allowed to react for 30 min in the dark. Indolic compounds were determined spectrophotometrically at 540 nm. Results are expressed in micrograms of total indolic compounds per milligram of protein, using IAA as standard. Protein content was estimated as described (Bradford 1976).
2.4.3 Siderophores
Strains were screened for the quantitatively production of siderophores (Schwyn and Neilands 1987). The bacteria were cultured on free-iron MM9 culture media for 72 h. Afterwards, a 1.0-mL aliquot from culture was centrifuged at 10,000 rpm for 5.0 min, and 0.5-mL supernatant was taken and allowed to react with 0.5 mL Chrome Azurol S assay solution. The mix was allowed to stabilize for 6.0 h, and after, absorbance was measured at 630 nm. The standard curve was elaborated using 20–100 μM deferoxamine mesylate (DFMO).
2.5 Bioaccumulation of Cu by Bacterial Strains
Strains were cultured on LBM medium for 24 h. Then, the cells were centrifuged at 10,000 rpm for 5.0 min and rinsed twice in 0.85% NaCl. The OD600 was adjusted at 0.200, again centrifuged, and the supernatant discarded. The pellets were resuspended in 1.0 mL of 37.5, 75, and 150 μg mL−1 Cu(II) adjusted to pH 5, and these were incubated for 6 h. After a time, the cultures were newly centrifuged and supernatant analyzed for copper content by atomic absorption spectrophotometry—AAS (AAS 2380, PerkinElmer, USA). Bacterial biomass was estimated according to Chen et al. (2005).
2.6 Growth on Aromatic Compounds
Bushnell Haas (BH) medium (composition: MgSO4 0.200, CaCl2 0.020, KH2PO4 1.000, K2HPO4 1.000, NH4NO3 1.000, and FeCl3 0.050 g/L, pH = 7.0) was employed for testing bacterial growth on aromatic compounds as a sole carbon source. For phenol and sodium benzoate degradation test was used BH liquid medium supplemented at 2.0 mM with the aromatic compound; the flasks were incubated at 28°C for 2–5 days at 180 rpm. Flasks without carbon source and with 1% glucose were used as negative and positive controls for bacterial growth, respectively. Bacterial growth was monitored spectrophotometrically at 600 nm. For toluene and m-xylene degradation test was employed growth in agar (1.8% [wt/vol]) plates with 1,000 μL of the volatile aromatic compounds, which were independently added on filter paper circles (9-cm diameters) placed in the lids of petri dishes. These were sealed with polyethylene tape and incubated upside down within closed polypropylene containers at 28°C. As controls were employed the same treatments mentioned above. Each strain was cultured three times in BH medium supplemented with adequate carbon source for ensuring aromatic hydrocarbon bacterial degradation.
2.7 Soil Analysis and Preparation
Soil samples were collected from the Corpoica Garden, and these were representative of the Altiplano Cundiboyancence (High Plateau of the Departments of Cundinamarca and Boyacá), Colombia. Once collected, the soil was air-dried at room temperature until 8% humidity was reached, and when it was dry, this was sieved at 2.0 mm. The soil was autoclaved three times in three consecutive days and finally allowed to stand for 8 days for stabilization. The basic soil properties were: organic matter 15.15 ± 0.21%, effective cationic interchange coefficient 8.26 ± 1.81 cmol/kg, pH 5.95 ± 0.07, total phosphorus 13.6 ± 0.70 mg/kg, total sulfur 12.6 ± 0.7 mg/kg, electric conductivity 0.69 ± 0.20 dS/m, total iron 134.5 ± 16.2 mg/kg, and total copper 1.85 ± 0.07 mg/kg.
2.8 Influence of PGPB and Cu on Growth of Sunflower and Copper Uptake
Helianthus annuus seeds were surface sterilized with 1.0% NaClO for 10 min and rinsed several times in deionized-sterilized water. The seeds were pre-germinated on sterilized peat for 5 days. After, the seedlings were submerged in a bacterial suspension adjusted to OD600 = 1.000 or in sterilized water for controls and planted. The pots containing 400 g of dry soil were intentionally contaminated until 200 ppm Cu(II) was reached with a concentrated solution of CuSO4·5H2O applied to each pot for ensuring the amount of copper added and allowed to stabilize for 2 weeks; total copper concentration was verified by AAS. Plants were grown in a glasshouse at 15–25°C and 16:8 day/night regime. After 21 days, the plants were carefully removed from the pots, and the root surface was cleaned several times with distilled water. Growth parameters as shoot and root length and shoot and dry weight (DW), were determined. Similarly, photosynthetic pigment content was measured (Hiscox and Israelstam 1979), with the equations proposed by Wellburn (1994). The copper content was measured on sunflower shoots and roots. The vegetal tissue was oven-dried at 60°C for 48 h, ground separately, and after, 200 mg of either dry shoot or root was mixed with 65% HNO3—30% H2O2 in relation 1:1 to a final volume of 12.0 mL. The mixes were subjected to microwave digestion for 2.0 h at 150°C, where after, the tubes were completed to volume 20 mL and copper content estimated by AAS (AAS 2380, PerkinElmer, USA).
2.9 Statistical Analysis
The statistical analysis was carried out employing the SPSS 17.0 (SPSS Inc.) software. The analyses were done with 95% confidentiality. Honestly significant difference (HSD) Tukey test was used to discriminate between pair groups.
3 Results
3.1 Strains and Molecular Identification
The bacterial strains CC22, CC24, CC30, and CC33 were molecularly characterized on the basis of their 16S rDNA sequences. The partial sequences of 16S rDNA were matched against sequences present in GenBank using the BLASTn program. The highest sequence similarity clearly indicates that the strain CC22 was closed to Pseudomonas putida, CC24 to Enterobacter sakazakii, whereas CC30 and CC33 to Acinetobacter sp. The 16S rDNA sequences were deposited in the EMBL/GenBank database under accession numbers JN108875, JN121125, JN108876, and JN108877 for CC22, CC24, CC30, and CC33, respectively.
3.2 Minimal Inhibitory Concentration to Cu(II)
We evaluated the tolerance to Cu(II) of the isolates on liquid medium. Further, we evaluated the influence of the culture media on the MIC to Cu(II). Results exhibited that increasing Cu(II) concentration led to bacterial growth inhibition, also that culture media complexity determinately influenced the MIC to Cu(II) (Table 1). We evidenced that as culture media were more complex, the MIC was higher, evidencing that Cu(II) is strongly bounded by media components such as organic ligands or inorganic ions. For instance, on LBM culture medium, the MIC was almost one- and twofold higher than on 0.66× LBM and 0.33× LBM, respectively, and on minimal MM9 medium, it was almost 70 times lower than on LBM (Table 1).
3.3 Plant Growth-Promoting Features of Strains
We characterized three PGP features (indole synthesis, phosphate solubilization, and siderophores production) in order to select one strain and evaluate its role on phytoextraction process (Fig. 1). Regarding indole, its synthesis was evaluated on minimal media supplemented with tryptophan. Among the isolates, Pseudomonas sp. CC22 and Acinetobacter sp. CC30 were the best. These were able to synthesize 59.8 and 61.2 μg indole/mg protein, while E. sakazakii sp. CC24 and Acinetobacter sp. CC33 produced 39.3 and 46.5 μg indole/mg protein, respectively (Fig. 1a). Further, bacteria were able to solubilize phosphate. Strains CC22 and CC30 solubilized the greatest amount of phosphorus, while CC24 and CC33 exhibited the lower rate. Pseudomonas sp. CC22 and Acinetobacter sp. CC30 solubilized between two- and fourfold more phosphates than the other strains (Fig. 1b). Additionally, all strains were able to synthesize siderophores in iron-free culture media MM9. However, no significantly differences were observed among strains. Bacteria tested were able to synthesize more than 100 μM siderophores relative to DFMO (Fig. 1c).
3.4 Biosorption of Copper by Bacterial Strains
The data expressing the capabilities of CC22, CC24, CC30, and CC33 to accumulate copper are illustrated in Fig. 2. Acinetobacter sp. CC33 exhibited the highest extent to accumulate Cu(II), and its ability was increased as copper did also. When the initial Cu(II) concentration was increased from 37.5 to 150 mg/L, the bioaccumulation capacity of CC33 increased from 8.7 to 19.8 mg/g (Fig. 2). In contrast, we observed that copper biosorption by CC22, CC24, and CC30 increased only from 37.5 to 75.0 mg/L suggesting that the biosorbents became likely saturated. The lowest extent of accumulation was evidenced by P. putida CC22 (Fig. 2). We explored copper accumulation after 6 h of incubation at pH 5.
3.5 Growth on Aromatic Compounds
Because the bacterial strains studied here were isolated from highly polluted soils with hydrocarbons, we decided to explore their intrinsic capacity to degrade aromatic compounds on culture media. The abilities of the bacteria to grow on aromatic compound as carbon sources were variable and dependent on each genus, although no strain was able to degrade m-xylene (Table 2). P. putida CC22 and Acinetobacter sp. CC30 and CC33 were able to use phenol and sodium benzoate as a sole carbon source, whereas CC30 was the only one able to metabolize toluene on the conditions tested. Conversely, CC24 was not able to grow on any of the aromatic compounds tested (Table 2).
3.6 Influence of Bacterial Inoculation on the Growth of H. annuus
We tested the influence of Acinetobacter sp. CC30 inoculation on both non- and Cu-contaminated soil to assess its role on plant growth promotion; this strain was chosen by its PGP features in vitro (Fig. 1). The inoculation of CC30 had significant effects on plant biomass (length and weight) on non- and Cu-contaminated soil (p < 0.05) (Fig. 3). In non-contaminated soil, the bacterial inoculation showed increased root length, and root DW by 17.9%, 21.4% and 63.2%, respectively (Fig. 3a, b). Whereas in contaminated, CC30 improved shoot and root length and shoot and root DW by 10.9%, 21.3%, 4.14% and 29.9%, respectively (Fig. 3a, b). These results evidenced that CC30 inoculation could play an important role on plant growth. Moreover, we investigated the role of bacterial inoculation on the plant photosynthetic pigment content. Results exhibited that the content of photosynthetic pigments was improved with respect to control without bacteria by the inoculation with Acinetobacter sp. CC30. When the soil was non-contaminated, an increase of 20.7%, 58.3%, and 20.6% was observed for chlorophyll A (chlA), chlorophyll B (chlB), and total carotenoids (x + c) content, respectively, whereas in Cu-contaminated soil, the increase was of 10.2% and 7.5% for chlA and chlB, respectively. We did not observe bacterial effect on the x + c amount (Table 3).
3.7 Effect of Acinetobacter sp. CC30 Inoculation on Copper Accumulation
Based on the bacterial plant growth-promoting features, Acinetobacter sp. CC30 was selected for pot experiments. Several studies have evidenced that bacteria can enhance metal uptake by plants through certain bacterial mechanisms such as organic acid syntheses or production of siderophores (Glick 2010). Our results evidenced that inoculation improved heavy metal uptake by plants (Fig. 4). While accumulation was increased in roots, no effect was observed on shoot copper content after 3 weeks with respect to control (Fig. 4). When Acinetobacter sp. CC30 was present, the copper uptake in roots was improved from 99.0 ± 1.4 to 139.0 ± 21.0 μg Cu mL−1. These results showed that inoculation with CC30 had a significantly effect on copper accumulation.
4 Discussion
Several strategies have been proposed in order to remove heavy metal pollution from the environment (Pulford and Watson 2003). One of the most widely accepted is phytoextraction, the utilization of plants to extract metals from soil (Lasat 2002; Lesage et al. 2005). Here, the use of bacteria with PGP capabilities and heavy metal resistance has been elucidated to be a relevant alternative to improve the efficiency of the process (Glick 2010). In the present study, we characterized four bacteria previously isolated from heavy metal- and hydrocarbon-contaminated soil (Dussán J., unpublished data) and selected one for pot experiments. The strains CC22, CC24, CC30, and CC33 were molecularly characterized as P. putida, E. sakazakii, Acinetobacter sp., and Acinetobacter sp. on the basis of their 16S rDNA sequences, respectively. We also established the extent of copper tolerance of bacterial strains by evaluating the microbial growth on four culture media (1× LBM, 0.66× LBM, 0.33× LBM, MM9) and several copper concentrations. Our results exhibited that bacteria tested had similar extents of tolerance to Cu(II) and that high copper concentrations led to bacterial growth inhibition (Table 1). Although copper is considered as an essential element for bacterial growth by being the constituent of several metalloenzymes, when it is at high concentrations, it becomes toxic for cells. This is mainly due to its interaction with nucleic acids and alteration of enzymes or membrane components, processes that can be related to the ability of Cu(II) to generate toxic hydroxyl free radicals (Cervantes and Gutierrez-Corona 1994). Moreover, we observed that the MIC to Cu(II) was severely affected by the culture media employed, where as medium complexity increased, the MIC to Cu(II) was higher (Table 1). Usually, it is argued that the presence of organic and/or inorganic chelators in the culture medium, which can generate organometallic complexes and insoluble salts, respectively, decreases the interaction among bacteria and copper and in consequence its toxic effect on microbial growth (Zevenhuizen et al. 1979).
There are several factors that define the efficiency of one phytoremediation process such as plant capacity to extract metals from soil, plant biomass or heavy metal availability in soil, etc. (Cataldo and Wildung 1978). In this study, we employed sunflowers (H. annuus) as plant for the bioremediation. This has been widely reported by its capacity to extract metals (Lesage et al. 2005; Mani et al. 2007; Turgut et al. 2004); however, there is little data about the effect of PGPB on efficiency of the phytoextraction processes. Therefore, we decided to evaluate the effect of bacterial inoculation on H. annuus growth. Acinetobacter sp. CC30 was the selected one for pot experiments on the basis of its PGP capabilities, where it exhibited the highest PGP capabilities in vitro (Fig. 1). These features measured in our study have been widely reported to influence significantly plant growth (Sheng and Xia 2006; Reed and Glick 2005; He et al. 2009). When Acinetobacter sp. CC30 was inoculated, an improvement in the growth of sunflowers was observed in both Cu- and non-contaminated soil, evidencing the role of CC30 as PGPB. This result is relevant because high copper levels generally generate plant growth repression (Ouzounidou 1995; Fernandes and Henriques 1991). In this study, bacterial inoculation partially reversed the deleterious effect occasioned by Cu(II) on plant growth, which has further implications on phytoextraction process because it represents a major soil exploration by roots for nutrient uptake, water and the pollutant agent; also, there is more capacity for Cu(II) accumulation due to the increased plant biomass. Glick (2010) reported that the effect of PGPB on plant growth under adverse condition might be the result of several bacterial mechanisms acting individually or simultaneously. For instance, synthesis of indolic compounds has shown to influence strongly plant growth and development controlling many important physiological processes including cell enlargement and division, tissue differentiation, and responses to light and gravity (Teale et al. 2006). Nevertheless, the effect is not always positive; it depends on the type, amount, availability, and sensitivity of the plant tissue to indole presence (Spaepen et al. 2007). Additionally, the ability to solubilize phosphorus may influence P availability in soil. Mechanisms associated to this trait are related to synthesis of organic acids and the activity of phosphatase enzymes that release P from inorganic and organic phosphorus compounds, respectively. However, organic acid liberation is not specific and may result in solubilization of other essential elements contributing to plant growth. Similarly, synthesis of siderophores, which are only produced under iron starvation, may play an important role in preventing pathogen infection and lack of iron in plants (Neilands 1995), hence contributing to plant nutrition. Also, some siderophores may be non-specific consequently improving the availability of other metals such as copper in soil for plant uptake. We observed that Acinetobacter sp. CC30 was able to synthesize indole and siderophores and solubilize phosphate; therefore, it is possible to argue that these traits may be related with these observations obtained in pot experiments where the plant was promoted under absence and presence of pollution by copper. Some authors reported the use of bacteria with these capabilities for improving phytoremediation processes. For instance, Rajkumar and Freitas (2008) reported the use of two PGPB strains tolerant to heavy metals and able to increase the growth of Ricinus communis in a soil contaminated with nickel, copper, and zinc. In the same way, Sheng et al. (2008) exposed that inoculation of Brassica napus with Pseudomonas fluorescens G10 and Microbacterium sp. G16 allowed to increase plant growth with consequent effects on phytoremediation process. We additionally explored the effect of bacterial inoculation on the content of photosynthetic pigments. We could observe that inoculation increased the amount of photosynthetic pigments in plants (Table 3). Usually, heavy metal contamination in soil is associated with iron deficiency in some plant species (Wallace et al. 1992), where low iron content generally inhibits chlorophyll biosynthesis (Dell'Amico et al. 2008). The bacterium employed for pot experiments was able to synthesize siderophores, likely improving iron nutrition in the plant, although there are other bacterial mechanisms that could be involved in this phenomenon. We also observed that under Cu contamination, the chlorophyll content without bacterial inoculation was higher. Drazkiewicz and Baszynski (2005) reported similar results in maize employing cadmium as pollutant agent. They found that at 100 μM Cd(II), the concentration of chlA + chlB was increased with respect to non-contaminated treatment. Their conclusions were directed to Cd-mediated effects on leaf surface size that led to major amount of Chl per area unity.
In this study, we observed a significant effect on Cu uptake mediated by CC30 inoculation (Fig. 4) (p < 0.05). This accumulation was principally exhibited in roots evidencing an increase in copper availability in soil. Authors as Chen et al. (2005) have reported that bacterial inoculation could improve the level of water-soluble copper extracted from soil. Likely an enhancing in Cu availability could be generated by bacterial activity, where the bacterial capacity to solubilize phosphates by synthesizing organic acids or chelating agents could have an important effect (Khan 2005; Glick 2010). This is mainly because in soil, Cu is strongly bounded to organic matter, and consequently, its availability is generally restricted (Lasat 2002). Jiang et al. (2008) observed the same effect, where bacteria able to solubilize heavy metals such as Pb and Cd were able to increase the plant metal uptake level in soil. In addition to the bacterial capacities to promote plant growth and for increasing the amount of copper extracted from soil, we observed that bacteria were able to accumulate Cu(II) and to use aromatic hydrocarbons as a sole carbon source. Thus, PGPB could have contributed in reducing the phytotoxic effects of Cu(II) by sharing the metal load due to its demonstrated ability of biosorption and bioaccumulation (Zaidi and Musarrat 2005). Adsorption of heavy metals can occur either with the live or dead cells, an effect that is attributed to the anionic nature of its cell surface. Moreover, bacteria were able to metabolize aromatic hydrocarbons. This property confers them more capacity to compete for nutrients with other soil bacteria taking account that the soil employed for bacterial isolation was highly contaminated with oil.
In conclusion, we exhibited that Acinetobacter sp. CC30 influenced significantly plant growth, fitness, and copper uptake, likely through several mechanisms related with improvement in plant mineral nutrition or with regulation of plant development by synthesizing like-phytohormone compounds. Further, we evidenced their intrinsically abilities to bioaccumulate copper and to degrade aromatic hydrocarbons suggesting more competitiveness against other bacteria on contaminated soils. Hence, the utilization of PGPB improved the phytoextraction process of Cu by H. annuus. However, further research is necessary in order to use this PGPB to optimize phytoextraction process, furthermore, for designing biological inoculants to use in contaminated fields. To our knowledge, this is one of the first studies where the bacterial role on the phytoextraction process of copper by sunflower is evaluated. We exhibited the strong influence of bacteria on the efficiency of the sunflower plant to remove copper from soil.
References
Abdelly, C., Öztürk, M., Ashraf, M., Grignon, C., Mediouni, C., Houlné, G., et al. (2008). Cadmium and copper genotoxicity in plants. In: Biosaline Agriculture and High Salinity Tolerance (pp. 325–333): Birkhäuser Basel.
Arnon, D. I., & Stout, P. R. (1939). The essentiality of certain elements in minute quantity for plants with special reference to copper. Plant Physiology, 14(2), 371–375.
Bradford, M. M. (1976). A rapid and sensitive method for the quantitation of microgram quantities of protein utilizing the principle of protein-dye binding. Analytical Biochemistry, 72, 248–254.
Carreno-Lopez, R., Campos-Reales, N., Elmerich, C., & Baca, B. E. (2000). Physiological evidence for differently regulated tryptophan-dependent pathways for indole-3-acetic acid synthesis in Azospirillum brasilense. Molecular and General Genetics, 264(4), 521–530.
Cataldo, D. A., & Wildung, R. E. (1978). Soil and plant factors influencing the accumulation of heavy metals by plants. Environmental Health Perspectives, 27, 149–159.
Cervantes, C., & Gutierrez-Corona, F. (1994). Copper resistance mechanisms in bacteria and fungi. FEMS Microbiology Reviews, 14(2), 121–137.
Chen, X. C., Wang, Y. P., Lin, Q., Shi, J. Y., Wu, W. X., & Chen, Y. X. (2005). Biosorption of copper(II) and zinc(II) from aqueous solution by Pseudomonas putida CZ1. Colloids and Surfaces. B, Biointerfaces, 46(2), 101–107.
Costacurta, A., & Vanderleyden, J. (1995). Synthesis of phytohormones by plant-associated bacteria. Critical Reviews in Microbiology, 21(1), 1–18.
Dell'Amico, E., Cavalca, L., & Andreoni, V. (2008). Improvement of Brassica napus growth under cadmium stress by cadmium-resistant rhizobacteria. Soil biology & Biochemistry, 40(1), 74–84.
Drazkiewicz, M., & Baszynski, T. (2005). Growth parameters and photosynthetic pigments in leaf segments of Zea mays exposed to cadmium, as related to protection mechanisms. Journal of Plant Physiology, 162(9), 1013–1021.
Evangelou, M. W., Bauer, U., Ebel, M., & Schaeffer, A. (2007). The influence of EDDS and EDTA on the uptake of heavy metals of Cd and Cu from soil with tobacco Nicotiana tabacum. Chemosphere, 68(2), 345–353.
Fernandes, J., & Henriques, F. (1991). Biochemical, physiological, and structural effects of excess copper in plants. The Botanical Review, 57(3), 246–273.
Fierer, N., & Jackson, R. B. (2006). The diversity and biogeography of soil bacterial communities. Proceedings of the National Academy of Sciences of the United States of America, 103(3), 626–631.
Fiske, C. H., & Subbarow, Y. (1925). The colorimetric determination of phosphorus. Journal of Biological Chemistry, 66, 375–400.
Flemming, C. A., & Trevors, J. T. (1989). Copper toxicity and chemistry in the environment: a review. Water, Air, and Soil Pollution, 44(1), 143–158.
Glick, B. R. (2010). Using soil bacteria to facilitate phytoremediation. Biotechnology Advances, 28(3), 367–374.
Glickmann, E., & Dessaux, Y. (1995). A critical examination of the specificity of the salkowski reagent for indolic compounds produced by phytopathogenic bacteria. Applied and Environmental Microbiology, 61(2), 793–796.
He, L. Y., Chen, Z. J., Ren, G. D., Zhang, Y. F., Qian, M., & Sheng, X. F. (2009). Increased cadmium and lead uptake of a cadmium hyperaccumulator tomato by cadmium-resistant bacteria. Ecotoxicology and Environmental Safety, 72(5), 1343–1348.
Hiscox, J. D., & Israelstam, G. F. (1979). A method for the extraction of chlorophyll from leaf tissue without maceration. Canadian Journal of Botanic, 57, 1332–1334.
Jiang, C.-Y., Sheng, X.-F., Qian, M., & Wang, Q.-Y. (2008). Isolation and characterization of a heavy metal-resistant Burkholderia sp. from heavy metal-contaminated paddy field soil and its potential in promoting plant growth and heavy metal accumulation in metal-polluted soil. Chemosphere, 72(2), 157–164.
Khan, A. G. (2005). Role of soil microbes in the rhizospheres of plants growing on trace metal contaminated soils in phytoremediation. Journal of Trace Elements in Medicine and Biology, 18(4), 355–364.
Lasat, M. M. (2002). Phytoextraction of toxic metals: a review of biological mechanisms. Journal of Environmental Quality, 31(1), 109–120.
Lesage, E., Meers, E., Vervaeke, P., Lamsal, S., Hopgood, M., Tack, F. M., et al. (2005). Enhanced phytoextraction: II. Effect of EDTA and citric acid on heavy metal uptake by Helianthus annuus from a calcareous soil. International Journal of Phytoremediation, 7(2), 143–152.
Ma, Y., Rajkumar, M., & Freitas, H. (2009). Inoculation of plant growth promoting bacterium Achromobacter xylosoxidans strain Ax10 for the improvement of copper phytoextraction by Brassica juncea. Journal of Environmental Management, 90(2), 831–837.
Mani, D., Sharma, B., & Kumar, C. (2007). Phytoaccumulation, interaction, toxicity and remediation of cadmium from Helianthus annuus L. (sunflower). Bulletin of Environmental Contamination and Toxicology, 79(1), 71–79.
Maniatis, T., Fritsch, E. F., & Sambrook, J. (1982). Molecular cloning: a laboratory manual. New York: Cold Spring Harbor Laboratory. N.Y.: Cold Spring Harbor.
Nehnevajova, E., Herzig, R., Federer, G., Erismann, K. H., & Schwitzguebel, J. P. (2005). Screening of sunflower cultivars for metal phytoextraction in a contaminated field prior to mutagenesis. International Journal of Phytoremediation, 7(4), 337–349.
Neilands, J. B. (1995). Siderophores: structure and function of microbial iron transport compounds. Journal of Biological Chemistry, 270(45), 26723–26726.
Ouzounidou, G. (1995). Cu-ions mediated changes in growth, chlorophyll and other ion contents in a Cu-tolerant Koeleria splendens. Biologia Plantarum, 37(1), 71–78.
Pikovskaya, R. I. (1948). Mobilization of phosphorus in soil in connection with vital activity of some microbial species. Mikrobiologiya, 17, 863–871.
Pulford, I. D., & Watson, C. (2003). Phytoremediation of heavy metal-contaminated land by trees–a review. Environment International, 29(4), 529–540.
Rajkumar, M., & Freitas, H. (2008). Influence of metal resistant-plant growth-promoting bacteria on the growth of Ricinus communis in soil contaminated with heavy metals. Chemosphere, 71(5), 834–842.
Reed, M. L., & Glick, B. R. (2005). Growth of canola (Brassica napus) in the presence of plant growth-promoting bacteria and either copper or polycyclic aromatic hydrocarbons. Canadian Journal of Microbiology, 51(12), 1061–1069.
RodrÌguez, H., & Fraga, R. (1999). Phosphate solubilizing bacteria and their role in plant growth promotion. Biotechnology Advances, 17(4–5), 319–339.
Schwyn, B., & Neilands, J. B. (1987). Universal chemical assay for the detection and determination of siderophores. Analytical Biochemistry, 160(1), 47–56.
Sheng, X. F., & Xia, J. J. (2006). Improvement of rape (Brassica napus) plant growth and cadmium uptake by cadmium-resistant bacteria. Chemosphere, 64(6), 1036–1042.
Sheng, X. F., Xia, J. J., Jiang, C. Y., He, L. Y., & Qian, M. (2008). Characterization of heavy metal-resistant endophytic bacteria from rape (Brassica napus) roots and their potential in promoting the growth and lead accumulation of rape. Environmental Pollution, 156(3), 1164–1170.
Sommer, A. L. (1931). Copper as an essential for plant growth. Plant Physiology, 6(2), 339–345.
Spaepen, S., Vanderleyden, J., & Remans, R. (2007). Indole-3-acetic acid in microbial and microorganism-plant signaling. FEMS Microbiology Reviews, 31(4), 425–448.
Tandy, S., Schulin, R., & Nowack, B. (2006). The influence of EDDS on the uptake of heavy metals in hydroponically grown sunflowers. Chemosphere, 62(9), 1454–1463.
Tanyolac, D., Ekmekci, Y., & Unalan, S. (2007). Changes in photochemical and antioxidant enzyme activities in maize (Zea mays L.) leaves exposed to excess copper. Chemosphere, 67(1), 89–98.
Teale, W. D., Paponov, I. A., & Palme, K. (2006). Auxin in action: signalling, transport and the control of plant growth and development. Nature Reviews. Molecular Cell Biology, 7(11), 847–859.
Turgut, C., Katie Pepe, M., & Cutright, T. J. (2004). The effect of EDTA and citric acid on phytoremediation of Cd, Cr, and Ni from soil using Helianthus annuus. Environmental Pollution, 131(1), 147–154.
Turgut, C., Pepe, M. K., & Cutright, T. J. (2005). The effect of EDTA on Helianthus annuus uptake, selectivity, and translocation of heavy metals when grown in Ohio, New Mexico and Colombia soils. Chemosphere, 58(8), 1087–1095.
Vandegrift, G. F., Reed, D. T., & Tasker, I. R. (1992). Environmental remediation: removing organic and metal ion pollutants (ACS symposium series; 509). Washington, DC: American Chemical Society.
Wallace, A., Wallace, G. A., & Cha, J. W. (1992). Some modifications in trace metal toxicities and deficiencies in plants resulting from interactions with other elements and chelating agents–the special case of iron. Journal of Plant Nutrition, 15(10), 1589–1598.
Wellburn, A. (1994). The spectral determination of chlorophylls a and b, as well as total carotenoids, using various solvents with spectrophotometers of different resolution. Jounal of Plant Physiology, 144, 307–313.
Zaidi, S., & Musarrat, J. (2005). Characterization and nickel sorption kinetics of a new metal hyper-accumulator Bacillus sp. Journal of Environmental Science and Health. Part A, Toxic/Hazardous Substances & Environmental Engineering, 39(3), 681–691.
Zevenhuizen, L. P. T. M., Dolfing, J., Eshuis, E. J., & Scholten-Koerselman, I. J. (1979). Inhibitory effects of copper on bacteria related to the free ion concentration. Microbial Ecology, 5(2), 139–146.
Acknowledgments
The authors thank Facultad de Ciencias Biológicas of Universidad de los Andes in Colombia and Centro de Biotecnología y Bioindustria (CBB) by its auspice and support. In the same way, thanks to Laboratorio de Microbiología de Suelos of Centro de Biotecnología y Bioindustria–Corpoica and Centro de Investigaciones Microbiológicas (CIMIC) of the Universidad de los Andes.
Author information
Authors and Affiliations
Corresponding author
Rights and permissions
About this article
Cite this article
Rojas-Tapias, D.F., Bonilla, R.R. & Dussán, J. Effect of Inoculation with Plant Growth-Promoting Bacteria on Growth and Copper Uptake by Sunflowers. Water Air Soil Pollut 223, 643–654 (2012). https://doi.org/10.1007/s11270-011-0889-3
Received:
Accepted:
Published:
Issue Date:
DOI: https://doi.org/10.1007/s11270-011-0889-3